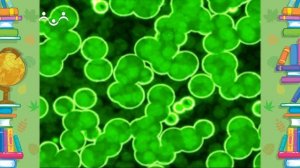
Школа Шишкиного Леса. Природоведение. Зеленушка

7:24
7:24
2024-01-24 14:00

 7:26
7:26

 7:26
7:26
2023-12-27 14:00

 1:51:54
1:51:54

 1:51:54
1:51:54
2026-06-20 09:00

 2:44:12
2:44:12

 2:44:12
2:44:12
2026-06-16 21:00

 1:57:45
1:57:45

 1:57:45
1:57:45
2026-06-07 21:00

 49:08
49:08

 49:08
49:08
2025-11-03 06:50

 3:12:39
3:12:39

 3:12:39
3:12:39
2026-04-02 00:05

 34:20
34:20

 34:20
34:20
2026-06-22 11:00

 29:16
29:16

 29:16
29:16
2026-06-22 13:38

 1:31:20
1:31:20

 1:31:20
1:31:20
2026-06-19 13:33

 57:01
57:01

 57:01
57:01
2024-09-29 00:51

 1:34:43
1:34:43

 1:34:43
1:34:43
2025-07-05 18:00

 2:27:43
2:27:43

 2:27:43
2:27:43
2025-05-17 22:00

 31:08
31:08

 31:08
31:08
2026-06-19 10:53

 1:30:59
1:30:59

 1:30:59
1:30:59
2025-07-10 18:00

 1:42:23
1:42:23

 1:42:23
1:42:23
2024-01-13 12:16

 57:13
57:13

 57:13
57:13
2025-10-30 20:24

 1:37:31
1:37:31
![Ярослав Леонов - Майская роза (Премьера клипа 2026)]() 3:14
3:14
![Фати Царикаева - Моё лето (Премьера клипа 2026)]() 2:22
2:22
![Рустам Нахушев - Жизнь как будто хороша (Премьера клипа 2026)]() 3:08
3:08
![Ислам Итляшев - Сердце (Премьера клипа 2026)]() 3:10
3:10
![Олег Семенов - Попутчица (Премьера клипа 2026)]() 3:00
3:00
![Enrasta - Бейби ту найт (Премьера клипа 2026)]() 2:44
2:44
![Рейсан Магомедкеримов - Роза алая (Премьера клипа 2026)]() 3:52
3:52
![Misty - Летай (Премьера клипа 2026)]() 2:30
2:30
![Соня Белькевич - Давай, танцуй (Премьера клипа 2026)]() 3:40
3:40
![Ислам Мальсуйгенов и Зульфия Чотчаева - Путеводная (Премьера клипа 2026)]() 3:15
3:15
![Стас Михайлов, Люся Чеботина - Обнимай (Премьера клипа 2026)]() 3:40
3:40
![ХАННА - Танцуй (Премьера 2026)]() 3:17
3:17
![Gran Error x ANTONIA - Levitate (Official Video 2026)]() 2:14
2:14
![Ислам Итляшев - Мужское сердце (Премьера клипа 2026)]() 3:24
3:24
![Murat Gamidov - По ночам (Премьера клипа 2026)]() 2:53
2:53
![NAIMAN - Королева (Премьера клипа 2026)]() 3:02
3:02
![Жасмин - Какое счастье (Премьера клипа 2026)]() 3:35
3:35
![Xhensila – Gjuma (Official Video 2026)]() 2:18
2:18
![KIDA - MENIME (Official Video 2026)]() 2:44
2:44
![Гоша Куценко, Юлия Пак - Твоя я (Премьера клипа 2026)]() 4:01
4:01
![Смертельно прекрасна | Pretty Lethal (2026)]() 1:30:46
1:30:46
![Необычайно умные создания | Remarkably Bright Creatures (2026)]() 1:54:04
1:54:04
![Эта штука работает? | Is This Thing On? (2026)]() 2:00:44
2:00:44
![Холостяк в Италии | Solo Mio (2026)]() 1:36:37
1:36:37
![Опасные отношения | Over Your Dead Body (2026)]() 1:45:24
1:45:24
![Напоминание о нём | Reminders of Him (2026)]() 1:54:16
1:54:16
![Властелины вселенной | Masters of the Universe (2026)]() 2:20:29
2:20:29
![Микки 17 | Mickey 17 (2025)]() 2:16:60
2:16:60
![Хищный рывок | Thrash (2026)]() 1:26:13
1:26:13
![Грозовой перевал | Wuthering Heights (2026)]() 2:16:14
2:16:14
![GOAT: Мечтай по-крупному | GOAT (2026)]() 1:39:46
1:39:46
![Мортал Комбат 2 | Mortal Kombat II (2026)]() 1:46:02
1:46:02
![Супер Марио: Галактическое кино | The Super Mario Galaxy Movie (2026)]() 1:38:18
1:38:18
![В чужой шкуре | Swapped (2026)]() 1:41:49
1:41:49
![Дьявол носит Prada 2 | The Devil Wears Prada 2 (2026)]() 1:51:51
1:51:51
![Полный такос | Operation Taco Gary's (2026)]() 1:26:14
1:26:14
![Вершина | Apex (2026)]() 1:35:30
1:35:30
![Мать Мария | Mother Mary (2026)]() 1:51:42
1:51:42
![Служебный роман | Office Romance (2026)]() 1:54:55
1:54:55
![Компаньон | Companion (2025)]() 1:37:08
1:37:08
![Мартышкины]() 7:10
7:10
![Тайны Медовой долины]() 7:01
7:01
![Сандра - сказочный детектив Сезон 1]() 13:52
13:52
![Киддеты]() 0:41
0:41
![Пластилинки]() 25:31
25:31
![Корги по имени Моко. Домашние животные]() 1:13
1:13
![Монсики]() 6:30
6:30
![Стражи Вселенной]() 1:04
1:04
![Умка]() 7:11
7:11
![Кадеты Баданаму Сезон 1]() 11:50
11:50
![Поймай Тинипин! Королевство эмоций]() 12:24
12:24
![Команда Дино Сезон 1]() 12:08
12:08
![Синдбад и семь галактик Сезон 1]() 10:23
10:23
![Корги по имени Моко. Волшебный мир снов]() 0:50
0:50
![Псэмми. Пять детей и волшебство Сезон 1]() 12:17
12:17
![Минифорс. Сила динозавров]() 12:51
12:51
![Оранжевая корова]() 6:30
6:30
![Мия и Коди]() 0:12
0:12
![Шахерезада. Нерассказанные истории Сезон 1]() 23:53
23:53
![Сборники «Ну, погоди!»]() 42:36
42:36
![Домовёнок Кузя]() 1:29:32
1:29:32
![Алдан (2025)]() 1:38:04
1:38:04
![Свои. Баллада о войне (2025)]() 1:29:27
1:29:27
![Маша и Медведь. Серия 1. Первая встреча]() 6:36
6:36
![Сборник На Кухне | Уральские Пельмени]() 1:30:27
1:30:27
![Зверополис | Zootopia (2016)]() 1:48:48
1:48:48
![Форсаж 6 | Furious 6 (2013)]() 2:11:07
2:11:07
![Лева Грузовичок все серии]() 43:59
43:59
![КЛИПЫ 80-90 х - ЗОЛОТЫЕ ХИТЫ - ЛЮБИМЫЕ ПЕСНИ]() 2:07:05
2:07:05
![🚀 ТОП Музыка 2026: Хиты на Все Времена! 🎵 Твои Любимые Исполнители 💎]() 2:48:18
2:48:18
![Сборник Новогодняя Десятка - Уральские Пельмени]() 1:19:08
1:19:08
![Три Кота | Сборник домашних приключений | Мультфильмы для детей]() 45:14
45:14
![Дьявол носит Prada | The Devil Wears Prada (2006)]() 1:49:29
1:49:29
![Гордость и предубеждение | Pride & Prejudice (2005)]() 2:08:21
2:08:21
![КАМИН 4К 🔥 FIREPLACE 4K | Звуки камина и Треск огня]() 2:00:00
2:00:00
![Инна Вальтер - Дымом лечилась (Исповедь хулиганки)]() 7:04
7:04
![Хищник: Планета смерти | Predator: Badlands (2025)]() 1:47:25
1:47:25
![Винни-Пух. 1969 год.]() 41:23
41:23
![Барбоскины. Сезон 1. Серия 1. Пчёлка]() 5:38
5:38
![Рыцарь семи королевств. Все серии]() 3:28:06
3:28:06

 1:37:31
1:37:31Скачать Видео с Рутуба по ссылке
| 256x144 | ||
| 432x232 | ||
| 640x360 | ||
| 856x480 | ||
| 1280x720 | ||
| 1920x1080 |
 3:14
3:14
2026-05-02 00:31
 2:22
2:22
2026-05-15 10:20
 3:08
3:08
2026-06-21 19:45
 3:10
3:10
2026-06-14 11:29
 3:00
3:00
2026-05-26 11:26
 2:44
2:44
2026-06-21 19:48
 3:52
3:52
2026-05-09 18:11
 2:30
2:30
2026-06-02 13:00
 3:40
3:40
2026-05-22 10:17
 3:15
3:15
2026-05-30 11:43
 3:40
3:40
2026-05-16 13:00
2026-06-14 11:27
 2:14
2:14
2026-05-16 13:24
 3:24
3:24
2026-05-15 09:58
 2:53
2:53
2026-05-21 14:27
 3:02
3:02
2026-05-26 10:55
 3:35
3:35
2026-05-16 13:07
 2:18
2:18
2026-05-10 12:39
 2:44
2:44
2026-05-10 12:47
 4:01
4:01
2026-05-21 11:24
0/0
 1:30:46
1:30:46
2026-03-28 23:09
 1:54:04
1:54:04
2026-05-12 16:55
 2:00:44
2:00:44
2026-05-04 16:12
 1:36:37
1:36:37
2026-06-17 13:01
 1:45:24
1:45:24
2026-06-05 12:15
 1:54:16
1:54:16
2026-05-28 20:15
 2:20:29
2:20:29
2026-06-21 22:48
 2:16:60
2:16:60
2026-05-07 15:07
 1:26:13
1:26:13
2026-04-29 20:33
 2:16:14
2:16:14
2026-04-20 11:54
 1:39:46
1:39:46
2026-06-01 17:19
 1:46:02
1:46:02
2026-05-18 11:14
 1:38:18
1:38:18
2026-05-12 16:55
 1:41:49
1:41:49
2026-05-06 10:44
 1:51:51
1:51:51
2026-05-06 10:53
 1:26:14
1:26:14
2026-04-07 11:13
 1:35:30
1:35:30
2026-04-30 16:00
 1:51:42
1:51:42
2026-05-26 13:06
 1:54:55
1:54:55
2026-06-21 22:48
 1:37:08
1:37:08
2026-05-07 15:10
0/0
 7:10
7:10
2025-12-30 18:33
 7:01
7:01
2022-03-30 17:25
2021-09-22 20:39
 0:41
0:41
2026-05-07 15:39
 25:31
25:31
2022-04-01 14:30
 1:13
1:13
2024-11-29 14:40
 6:30
6:30
2022-03-29 19:16
 1:04
1:04
2026-04-14 12:27
 7:11
7:11
2026-01-20 10:00
2021-09-22 21:17
 12:24
12:24
2024-11-27 13:24
2021-09-22 22:29
2021-09-22 23:09
 0:50
0:50
2026-05-07 17:13
2021-09-22 22:23
 12:51
12:51
2024-11-27 16:39
 6:30
6:30
2022-03-31 18:49
 0:12
0:12
2026-04-10 14:28
2021-09-22 23:25
 42:36
42:36
2025-08-26 12:07
0/0
2025-03-15 20:49
 1:38:04
1:38:04
2026-03-26 23:45
 1:29:27
1:29:27
2026-04-20 10:31
2015-02-06 15:18
2025-04-04 18:26
 1:48:48
1:48:48
2024-12-16 19:01
 2:11:07
2:11:07
2023-04-25 22:52
2022-09-16 07:26
2023-05-31 14:59
 2:48:18
2:48:18
2026-04-24 09:34
2026-01-01 13:59
 45:14
45:14
2020-04-22 20:10
 1:49:29
1:49:29
2023-04-27 15:40
 2:08:21
2:08:21
2023-05-03 20:56
2024-12-19 00:00
 7:04
7:04
2018-07-11 11:26
 1:47:25
1:47:25
2025-11-27 03:58
2023-11-19 12:01
 5:38
5:38
2023-12-25 15:26
 3:28:06
3:28:06
2026-02-24 11:12
0/0

